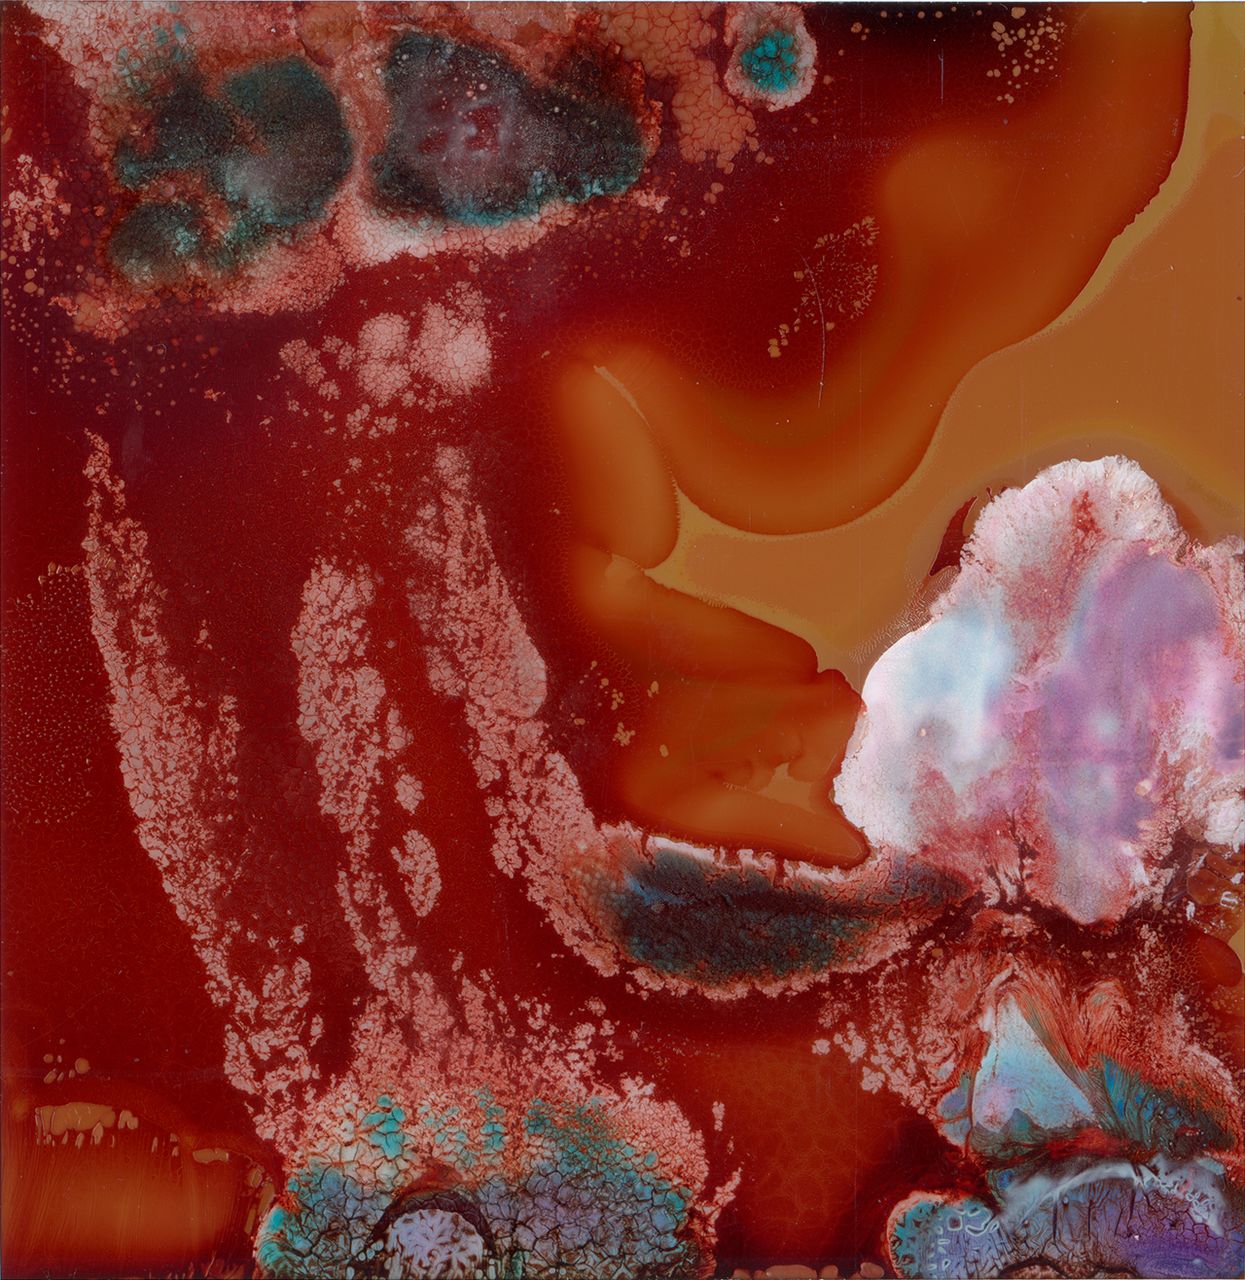

Checo Mogo
Ciudad de México, 1990
Vive y trabaja en Ciudad de México
Pienso en la imposibilidad de fotografiar aquello que se siente, pero no se ve. Me interesa explorar la correspondencia entre realidad y fotografía. ¿Es posible articular relaciones entre el universo de lo sensible y la imagen fotográfica? Porque de nosotros sólo es visible la superficie, la piel, pero lo sensible no se reduce a ella. Estudió Ingeniería Química en la Facultad de Química de la UNAM, el programa de la Escuela Activa de Fotografía Coyoacán, los programas para Latinoamérica impartidos por Proyecto Imaginario y el Seminario de Producción Fotográfica del Centro de la Imagen (2022). Ha trabajado como editor de fotografía para distintas agencias internacionales de noticias y como docente de la Escuela Activa de Fotografía. A través de su trabajo reflexiona sobre las relaciones de representación entre la imagen fotográfica y la realidad. Con ello busca formas de describir aquello que puede sentirse, pero no se ve.
Interferencias Sustantivas #21 (2022) 1.5 ml de sangre del artista inyectada en película instantánea antes de ser expuesta y revelada.

Interferencias: sustancias afectivas #11 (2022) 1.o ml de sangre del artista inyectada en película instantánea después de ser expuesta y revelada.

Interferencias: sustancias afectivas #24 (2022) 1.o ml de sangre del artista inyectada en película instantánea B&N antes de ser expuesta y revelada.

Sin Título (2021) Proceso de tricromía con filtros (RGB) en Película Portra 400.

Sin Título (2021) Proceso de tricromía con filtros (RGB) en Película Portra 400.





